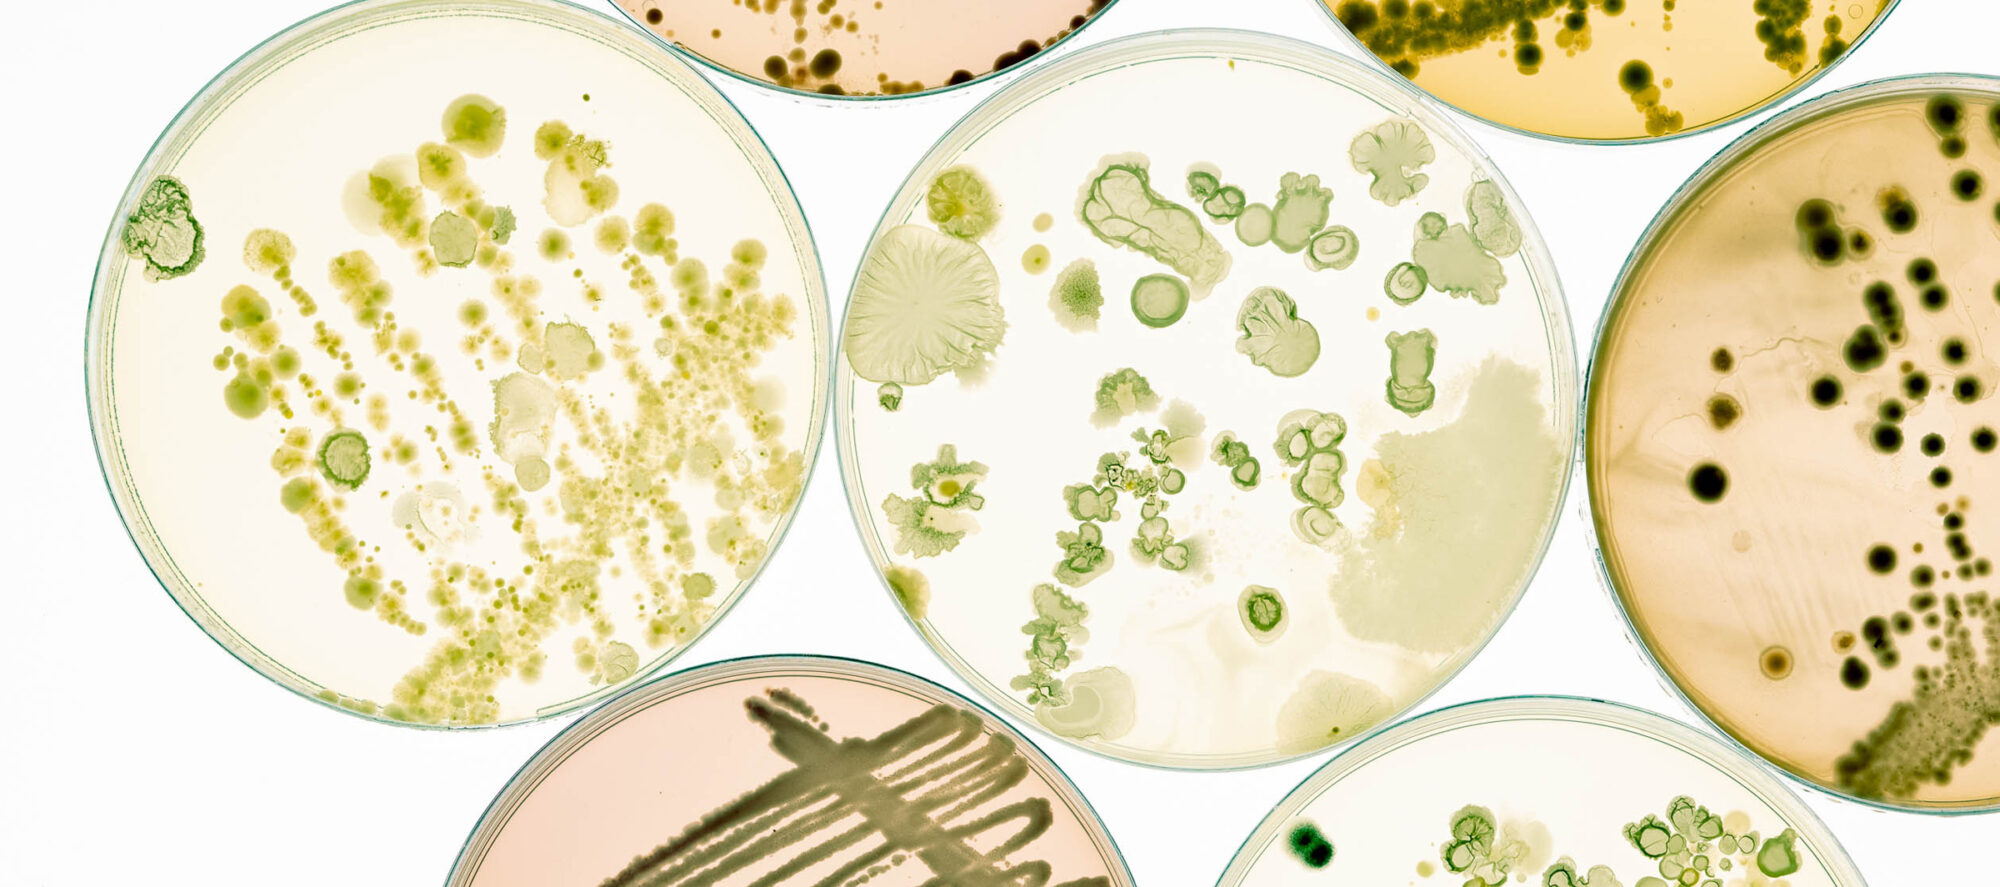

Biotechnologie
rospatt hat Mandanten im Biotechnologiebereich vertreten, seit es diese Branche gibt. Die Erfahrung von rospatt reicht von den Anfängen, als es noch Schutz für spezifische Nukleinsäuren und Proteine gab (z. B. im Bereich HCV und HIV), über Essay-Technologien, PCR-Technologien, Antikörper und Next Generation Sequencing (NGS) bis hin zu Impftechnologien und biologischen Arzneimitteln, einschließlich Biosimilars.